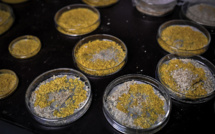

|
Insolite
Un "téléphone pour chiens" vise à atténuer leur solitude 18/11/2021
Londres, Royaume-Uni | AFP | mercredi 17/11/2021 - Finie, la solitude des chiens laissés seuls à la maison? Grâce à un appareil encore expérimental...
Charente-Maritime: trois tonnes d'huîtres volées sur l'île de Ré 12/11/2021
La Rochelle, France | AFP | jeudi 11/11/2021 - Trois tonnes d'huîtres commercialisables cet hiver ont été volées à un ostréiculteur de l'île de Ré...
Le CNRS recherche 10.000 passionnés du blob 21/10/2021
Paris, France | AFP | mercredi 20/10/2021 - Le CNRS a lancé mercredi un projet de science participative ouvert à 10.000 volontaires pour mener des...
"Flotter dans les airs", la nouvelle attraction immersive dans un gratte-ciel de New York 20/10/2021
New York, Etats-Unis | AFP | mardi 19/10/2021 - Les quelques chanceux qui ont pu s'immerger cette semaine dans la dernière attraction new-yorkaise...
Pas-de-Calais: un "grand félin" aperçu en liberté, des recherches en cours 14/10/2021
Lille, France | AFP | jeudi 14/10/2021 - Un "grand félin" a été aperçu mercredi soir en liberté près d'Auxi-le-Château (Pas-de-Calais), a indiqué...
La voyante ne tient pas ses promesses, son client la poursuit en justice 06/10/2021
Los Angeles, Etats-Unis | AFP | mardi 05/10/2021 - Un Américain a assigné en justice une voyante qui affirmait pouvoir lever une malédiction...
USA: des séquoias emballés dans de l'alumunium pour les protéger des incendies 17/09/2021
Los Angeles, Etats-Unis | AFP | jeudi 16/09/2021 - Les secours ont emballé jeudi dans des couvertures ignifugées des séquoias géants, les arbres les...
Un artiste devait exposer 70.000 euros de billets mais part avec l'argent 01/10/2021
Copenhague, Danemark | AFP | mercredi 29/09/2021 - Il devait exposer pour l'équivalent de plus de 70.000 euros de billets de banque collés sur une...
Des taxis de Bangkok convertis en potagers, faute de clients 15/09/2021
Bangkok, Thaïlande | AFP | mercredi 15/09/2021 - Des jardinets potagers et des mini-mares accueillant des grenouilles : les toits et capots de taxis...
Contre le pass sanitaire, le "Spider-Man français" escalade une tour à la Défense 07/09/2021
La Défense, France | AFP | mardi 07/09/2021 - A près de 60 ans, Alain Robert, surnommé le "Spider-Man français", a escaladé mardi à mains nues une...
|
||||
|
TAHITI-INFOS est un site édité par FENUACOMMUNICATION Sarl au capital de 20 000 000 Fcfp, immeuble Manarava - Shell RDO Faa'a - BP 40160 98 713 Papeete Polynésie Française.
(+689) 40 43 49 49 - Dir. de publication : Sarah MOUX - Gérant : Albert MOUX |
||||